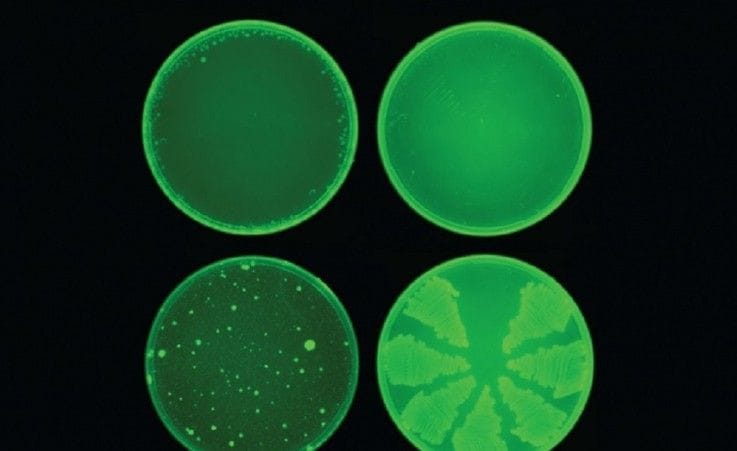

BRUXELLES - In Europa batteri che possono essere trasmessi con gli alimenti, come salmonella e campylobacter, diventano sempre più resistenti ad antibiotici specifici e difficili da curare, anche se negli ultimi anni si registrano "tendenze positive" negli allevamenti. Sono i dati dell'ultimo rapporto sull'antibiotico-resistenza nelle zoonosi (malattie che si trasmettono dagli animali all'uomo) pubblicato oggi dal Centro europeo per la prevenzione e il controllo delle malattie (Ecdc) e dall'Autorità europea per la sicurezza alimentare (Efsa).
Per l'Italia, nell'uomo la resistenza del campylobacter jejuni è alta per antibiotici di rilevanza essenziale, mentre i dati sugli allevamenti di pollame riportano livelli di resistenza piuttosto alta per i tre batteri esaminati. Ma negli allevamenti europei il livello di antibiotico resistenza per l'escherichia coli è in flessione.
"I risultati positivi negli animali sono incoraggianti - dichiara il direttore scientifico dell'Efsa Marta Hugas - dobbiamo tuttavia indagare ulteriormente sulle ragioni di questo cambiamento".
© RIPRODUZIONE RISERVATA








